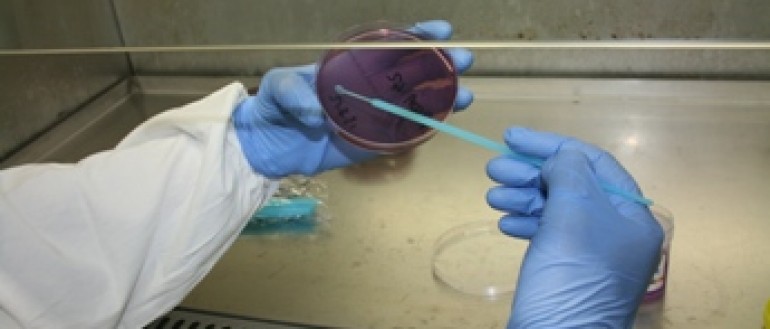

Our research focus:
- The diagnosis of a sexually transmitted infection (STI) in a child is often regarded as strong evidence that sexual abuse has occurred. Clearly, such a diagnosis has profound medico-legal implications, and the consequences of incorrect diagnosis can be devastating.
Our research impact:
- To investigate conceivable mechanisms by which 'false positive' diagnoses may occur. This information is essential for the numerical understanding of the power of STI diagnosis in a young child to indicate whether sexual abuse has occurred.
- One agent of particular interest is Chlamydia trachomatis, which causes both eye and urogenital infections. We are investigating the C. trachomatis population structure in the Northern Territory to determine if transmission from the eye to the urogenital site can occur.
- To investigate possible mechanisms that may result in very rare instances of diagnostic specimens becoming contaminated with STI agents from environmental clinic surfaces during the process of collection.
Key staff:
- Professor Phil Giffard
- Patiyan Andersson
- Dr Steven Tong
- Professor Bart Currie
- Rachael Lilliebridge.
Collaborators:
- Sexual Assault Referral Centre, Northern Territory Government
- Centre for Disease Control, Northern Territory Government
- Wellcome Trust Sanger Institute, Cambridge, UK
- University of Southampton, Southampton, UK.
- Andersson, P., Klein, M., Lilliebridge, R.A., & Giffard, P.M. (2013). Sequences of multiple bacterial genomes and a Chlamydia trachomatis genotype from direct sequencing of DNA derived from a vaginal swab diagnostic specimen. Clinical Microbiology and Infection. Advance online publication.